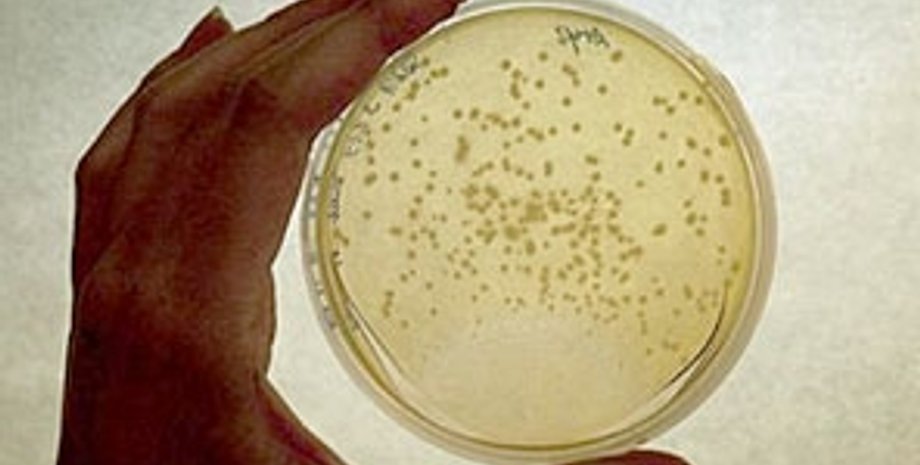

Обама разрешит изучать стволовые клетки
Президент США Барак Обама снимет запрет на государственное финансирование исследований стволовых клеток.
Запрет на использование федеральных денег в области исследований стволовых клеток был введен предыдущей администрацией республиканцев во главе с Джорджем Бушем в августе 2001 года. А в июне 2007 года Буш наложил вето на закон, который бы позволил снять эти ограничения.
Как сообщает Би-би-си, стволовые клетки представляют собой раннюю стадию развития клеток. Их можно превратить в клетки любых тканей организма. По мнению ученых, стволовые клетки помогут в разработке перспективных методов лечения многих болезней, особенно связанных с постепенным отмиранием тканей - например, рассеянного склероза и болезни Паркинсона.
Церковь и различные религиозные и общественные организации называют применение стволовых клеток неэтичным, поскольку до обнаружения новых способов получать эти клетки предполагалось, используя ткани человеческих эмбрионов.
Обама еще перед выборами пообещал, что при его администрации на науку не будет оказываться никакого политического давления.
